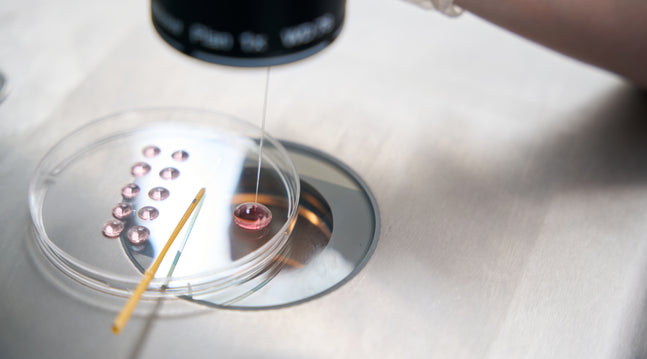

No matter how conditioned we are to it, the miracle of life will never not be awe-inducing.
Experiencing the love of parent and child is a feeling that words can only do so much to describe, but for those who want it, it can be difficult to drown out the pressure of getting pregnant quickly and traditionally.
Luckily, we are part of the generation that has both built and benefited from technological innovation, especially in the realm of pregnancy. From surrogacy to egg freezing, there are so many routes one can take in the journey of conception, including IVF.
Embarking on an IVF journey is an emotional and taxing feat, though the gift at the end of the tunnel is most certainly worth it. If you or a loved one are considering or somewhere along the IVF process, here’s a comprehensive guide for what to expect.
What is IVF?
In vitro fertilization, commonly known as IVF, is a form of fertility treatment in which an egg is fertilized in a laboratory with sperm, allowing the embryo to develop before being transferred to the uterus to increase the likelihood of pregnancy. This method is usually employed after simpler treatments to boost fertility are deemed unsuccessful.
There are a number of reasons why one may be experiencing infertility, from damaged fallopian tubes, to hormonal imbalance, to complications of endometriosis—and many more on the sperm side of things. Whatever the case may be, IVF can address these issues and boost one’s chances of carrying a healthy, full-term pregnancy. While an IVF success rate may start to drop off after the mid-30s, the odds still remain in the carrier’s favor.
What Are The Five Stages of IVF?
How long the IVF process takes can vary from individual to individual, though one full cycle of IVF typically takes about 2 to 3 weeks. However, it’s impossible to give an accurate IVF process step-by-step timeline, as some stages may last longer than others due to age, risks, and other factors. Regardless of the timing, there are five specific checkpoints you’ll always move through:
Stage 1: Boost Fertility with Superovulation
In preparation for your egg retrieval, you’ll receive a series of at-home injections or medications that will boost your natural production of eggs.
Known as stimulation or superovulation, these follicle-stimulating hormones will signal your body to produce more than just the normal one egg per month, increasing your chances of fertilization. The process will be thoroughly explained to you by your healthcare practitioner and is absolutely nothing to fear—most women have no issue tending to themselves during this stage.
Stage 2: Egg Retrieval
In preparation for your egg retrieval, you’ll receive a hormone injection that will help your eggs mature quickly. This will be followed by a minor surgical procedure called follicular aspiration, in which your doctor uses an ultrasound to guide a thin needle into each of your ovaries through your vagina that suctions the eggs out. While you’ll be sedated, you may experience light cramping following the procedure.
Stage 3: Collect Sperm
Whether you’re doing this alongside a partner or using donor sperm, at the third stage, sperm is collected to be used during insemination. A low number of sperm or unusual changes in their movement, size or shape can make it hard for sperm to fertilize an egg. A major factor in fertility is the health of the sperm used, which is why the laboratory will make sure to collect the most viable sperm from the sample to heighten the probability of success.
Stage 4: Insemination
Combining the best sperm with your best eggs, the fourth stage is called insemination. This process usually only takes a few hours, and your doctor may opt to inject the sperm directly into the egg, a process known as intracytoplasmic sperm injection.
Stage 5: Embryo Transfer
Following a medication that preps the lining of your uterus to receive your embryos, about three to five days after fertilization, your doctor will implant the embryos using a catheter in you or your gestational carrier (also known as a surrogate). You’ll be awake for the process, and can soon determine the success of the transfer by taking a pregnancy test.
What To Know Before Doing IVF
While this procedure can bring a miracle in your life, it’s important to stay informed. There are a few IVF pregnancy risks to bear in mind.
- IVF puts stress and strain on the body, mind, and finances
- There could be complications during egg retrieval
- There is risk of ovarian hyperstimulation syndrome
- There is risk of an ectopic pregnancy
Another thing to note is that twins or triplets are common outcomes of IVF. This is due to the fact that during the insemination process, multiple embryos are transferred in the hopes that at least one will implant itself. Sometimes more than one embryo ends up implanting, leading to multiples.
While the age of the mother is the main risk factor for birth defects, regardless of the method of conception, IVF is linked with a slightly higher risk of a baby being born with heart issues, digestive problems, or prematurely. More research needs to be done in order to determine the exact cause of IVF baby disadvantages.
Lastly, IVF is certainly not inexpensive. On average, you may have to undergo 2 or 3 rounds of IVF before achieving a successful pregnancy. With IVF treatment costing between $12k to $20k per cycle and many insurance companies not covering it, the out-of-pocket expenses can be jarring.
Determine Whether IVF is Right For You
The road to conception is always an emotional one, and it can be especially hard to navigate when going through the process of IVF. It’s important to have a solid support team around you, especially to hold you up as hormonal fluctuations and stress prove difficult to overcome.
In order to make the journey worth it, it’s important that you take the utmost care of your body during your IVF journey and follow your healthcare practitioner’s guidance to a T. Light exercise, eating healthy, and taking fertility-boosting supplements can support your body and aid you in the conception process. With faith, patience, and determination, there is a mighty bright light at the end of the tunnel.